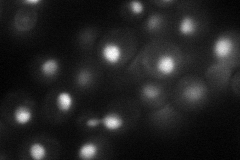
YLR033W
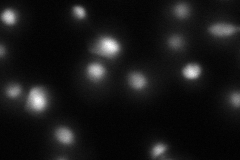
YLR033W
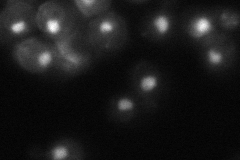
YLR033W

View description
Component of the RSC chromatin remodeling complex; RSC functions in transcriptional regulation and elongation, chromosome stability, and establishing sister chromatid cohesion; involved in telomere maintenance
Localization:
Intensity:
Fold change:
Significance:
-
C’ GFP library in SD

nucleus46.64 -
N' NOP1pr-GFP in SD
nucleus,nucleolus58.876 -
N' TEF2pr-mCherry in SD
nucleus,nucleolus21.3972 -
N' NATIVEpr-GFP in SD
nucleus43.668 -
N' TEF2pr-VC and Cyto-VN in SD

#N/A0 -
C’ GFP library in SD+DTT

nucleus53.121.13No -
C’ GFP library in SD+H2O2

nucleus45.790.98No -
C’ GFP library in Starvation Media

nucleus44.860.96No -
C’ GFP library on the background of Pup2-DaMP

nucleus -
C’ GFP library on the background of CCT mutant

nucleus54.6831.17225No
